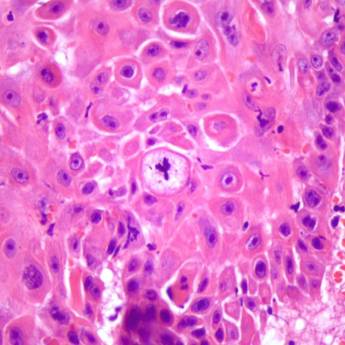
Comprar o produto de Histopatológico em Anatomia Patologica em Botucatu, SP por Solutudo
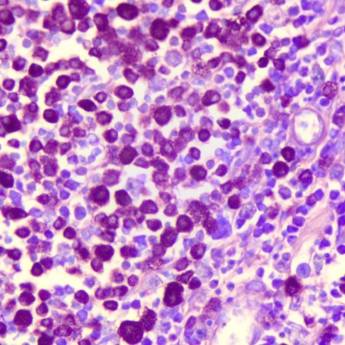
Comprar o produto de Colorações especiais em Anatomia Patologica em Botucatu, SP por Solutudo

Os melhores produtos e ofertas de
Centro de Diagnóstico por Imagem Veterinário em
Botucatu, SP
Onde comprar itens de Centro de Diagnóstico por Imagem Veterinário?
Reunimos os melhores produtos e as melhores ofertas de Centro de Diagnóstico por Imagem Veterinário em Botucatu, SP.